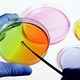
Maxresdefault

-
-Postula la teoría de Generación Espontánea.
-Formula la primera clasificación de la naturaleza.
-2 Reinos, Animal y Vegetal. -
-Publicación de su trabajo "De contagione et contagiosis morbus et curatione".
-Sospecha que seres vivos diminutos son causantes de enfermedades, tales como, la Peste, el Carbunco y la Tuberculosis. -
-Propone que la peste bubónica era provocada por un microorganismo infeccioso.
-
-Uno de los primeros cientificos en aventurarse en usar el microscopio para sus investigaciones
-Describe por primera vez a las bacterias -
-Refuta por primera vez la Teoría Espontanea en su libro "Experienze in torno de la generazione deg'Insetti"
-
-Desarrolló el sistema de nomenclatura binominal.
-
-Publica el Sistema Naturae, donde se presentaban determinadas reglas capaces de estandarizar la forma de designar a especies
-Propone 3 Reinos: Animal, Vegetal y Mineral -
-Nombrado director del departamento de ciencias naturales de la escuela normal en París
-Demuestra que los gérmenes se propagan por el aire
-Desmonta de manera total a la Teoría de la Generación Espontánea -
-En busqueda para determinar que afectaba el licor de remolacha, Pasteur comienza investigaciones
-Descubre estructuras baciliformes (bacteria del ácido láctico) en el licor agriado
-Somete al vino a un breve calentamiento, lo que permite eliminar a la bacteria. Método que se denominará Pasteurización -
-Demuestra la diferencia entre organismos unicelulares (protistas) y pluricelulares (plantas y animales)
-Su clasificación entra en la filosofía: Monistas (un solo reino como origen) y pluristas (más de un reino origen). -
-Investiga el Carbunco, enfermedad que afecta al ganado y en ocasiones al hombre, esta es causada por el Bacillus anthracis
-Realiza experimentos con ratones inyectándoles la bacteria, los cuales posteriormente mueren presentando los síntomas de la enfermedad -
-Es nombrado director del Departamento Imperial de Salud (Alemania), en donde realiza investigaciones bacteriológicas (Tuberculosis, Cólera, etc)
-
-Realiza experimentos con pollos para determinar los mecanismos de transmisión de la bacteria responsable del cólera aviar. Algunos de estos son inoculados con el agente patógeno del cólera, volviéndose inmunes
-
-Descubre el agente patógeno de la Tuberculosis, conocido como bacilo de Koch (Mycobacterium tuberculosis)
-Su método contra la Tuberculosis a base de Tuberculina resulta ineficaz, no obstante la tuberculina sirve para diagnosticar la Tuberculosis -
-Descubre el patógeno del cólera (Vibrio cholerae), también trabaja con la peste Bovina, la peste Bubónica, la Fiebre de Texas y la Malaria
-
-Comprueba a base de sus experimentos que un determinado Agente causa una determinada enfermedad
-
-Paralelamente al desarrollo de la vacuna contra el Cólera, Pasteur desarrolla la vacuna contra la Rabia.
-
-Se utiliza por primera vez la vacuna contra la rabia en un joven que había sido mordido por un perro que presentaba esta patología, resultado con éxito.
-
Clasifica a los seres vivos en 5 reinos: Monera, Protista, Fungi, Plantae y Animalia.
-
-Propone el sistema de los 3 dominios: Bacteria, Archaea y Eycarya.
-
-Ecological Society of America le otorga el premio "Ecólogo Eminente".
Plan projects on a visual timeline
Map milestones, phases, deadlines, and key events in one place so the sequence is easier to see and share. Timetoast is a timeline maker for work, school, research, and stories.